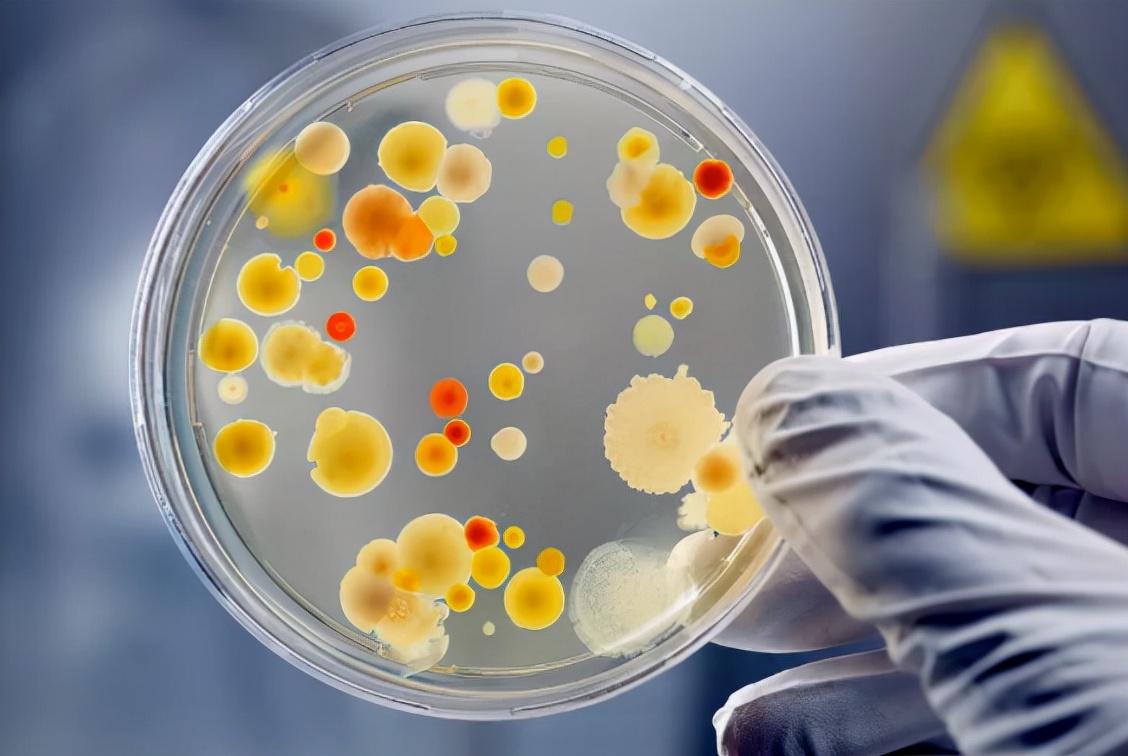
恒河牌矿泉水开售,10万瓶1小时内被抢光?恒河水到底有多脏?

恒河牌矿泉水

要健康从喝恒河水开始印度售恒河牌矿泉水引网友热议
图片尺寸600x552
要健康从喝恒河水开始?印度售恒河牌矿泉水引网友热议
图片尺寸572x605
要健康从喝恒河水开始?印度售恒河牌矿泉水引网友热议
图片尺寸440x587
网传印度想将刚开发的,"恒河矿泉水"推向中国,你敢买吗?
图片尺寸640x487
印度恒河被污染成这样竟推出恒河牌矿泉水还被抢购一空
图片尺寸660x372
恒河牌矿泉水2元一瓶,上架10万被抢空,世卫组织:大肠杆菌超标_当地人
图片尺寸1350x960
印度人想卖恒河水给中国,5元一瓶,还怕被抢购!
图片尺寸1280x720
10万瓶一小时抢光,恒河"矿泉水"那么脏,为啥印度人还抢着买?-度小视
图片尺寸528x700
恒河牌矿泉水畅销印度,一小时内抢光10万瓶!恒河水有多脏?
图片尺寸2443x1280
恒河牌矿泉水开售,10万瓶1小时内被抢光?恒河水到底有多脏?
图片尺寸1128x756
恒河牌矿泉水畅销印度,一小时内抢光10万瓶!恒河水有多脏?
图片尺寸2773x1280
恒河牌矿泉水畅销印度,一小时内抢光10万瓶!恒河水有多脏?
图片尺寸2447x1280
恒河商业化:印度人喝浑水还称之为矿泉水?
图片尺寸640x449
印度想将恒河水做成矿泉水卖入中国,还认为中国人会疯狂抢购
图片尺寸608x370
印度"恒河牌"矿泉水,国内卖得很火,商家有意向出口到中国?
图片尺寸700x393
恒河商业化:印度人喝浑水还称之为矿泉水?
图片尺寸640x430
印度恒河水标价5元一瓶,自以为能拿下中国市场,国人:痴人说梦
图片尺寸640x437
"印度恒河牌矿泉水,国内卖得很火,商家有意向出口到中国?
图片尺寸573x376
让印度人民极其热爱的恒河牌矿泉水,5块钱一瓶,你敢买来喝吗?
图片尺寸500x331
10万瓶一小时抢光,恒河"矿泉水"那么脏,为啥印度人还抢着买?
图片尺寸848x567